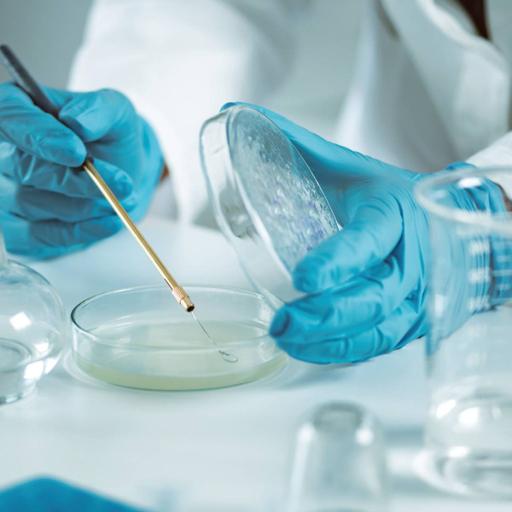

Arjun Julian
126 resources
A Graduate in Computer Application he prefers to be known as a content writer and a developer. Apart from content writing, he also does coding and has experience in various computer related languages.
View more
A Graduate in Computer Application he prefers to be known as a content writer and a developer. Apart from content writing, he also does coding and has experience in various computer related languages.
View more